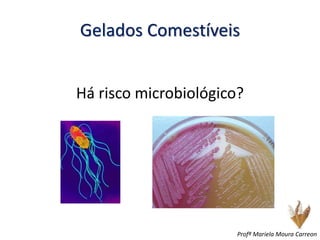
Gelados Comestíveis
Há risco microbiológico?
Profª Mariela Moura Carreon

O documento discute controle de qualidade em alimentos, mencionando boas práticas de fabricação, procedimentos operacionais padronizados e normas como ISO 22000. Também aborda gelados comestíveis, definindo identidade, classificação, processamento e requisitos microbiológicos para o produto.